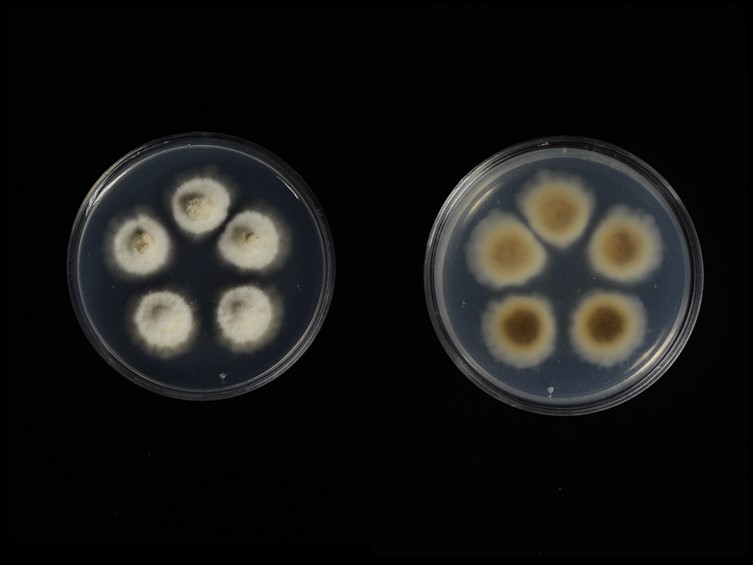

Holotype:
THAILAND, Nakhon Ratchasima Province, 9 Jul. 2012, K. Tasanathai, S. Mongkolsamrit, A. Khonsanit, W. Noisripoom, P. Srikitikulchai, K. Sansatchanon, R. Somnuk, holotype BBH 32211, ex-type living cultureTBRC 8102.
Habitat:
Leaf litter.
Host:
On Lepidoptera larvae.
Description:

Stroma solitary to several, cylindrical, 45–70 mm long, 0.5 mm wide, brown to dark brown. 
Perithecia superficial, densely packed covering lower part and loosely aggregated at the apex of stroma, ordinal in arrangement, ovoid, brown-dark brown, 340–420 × 240–310 μm. 
Asci hyaline, cylindrical, 8-spored, 110–225 × 5–7.5 μm. 
Ascospores whole, hyaline, filiform, with septation, 150–205 × 2 μm. Asexual morph: terminal, pale grey to dark grey, 4–5 mm long. Conidiogenous cells mono- or polyphialidic, hyaline, smooth. Phialides 12–16 μm, base 6–10 × 4–5 μm, neck 2–9 × 0.5–1 μm. Conidia hyaline, smooth, fusiform, 5–7 × 2 μm, surrounded by mucous sheath.
Culture characteristics:
Colonies on PDA attaining a diam of 20 mm in 20 d. Colonies pale orange to light brown, velvety, colony reverse pale orange to light brown after 20 d bearing 
conidiogenous cells and 
conidia of the Hirsutella asexual morph. Conidiogenous cells mono- or polyphialidic arising from hyphae laterally or terminally, hyaline, smooth. Phialides 22–30 μm, base 12–20 × 3–4 μm, neck undulate, 8–12 × 1 μm. Conidia hyaline, smooth, obovoid to citriform, 5–7 × 3–4 μm surrounded by mucous sheath.
Reference:
Luangsa-ard JJ, Tasanathai K, Thanakitpipattana D, et al. (2018). Novel and interesting Ophiocordyceps spp. (Ophiocordycipitaceae, Hypocreales) with superficial perithecia from Thailand. Studies in Mycology 89: 125–142.
DOI: https://doi.org/10.1016/j.simyco.2018.02.001Species |
Strain |
Compound |
Pubchem CID |
Biological activity |
Reference |
|---|
|
Strain |
- |
|---|---|
| TBRC 8101 | MF614645 |
| TBRC 8102 | MF614646 |